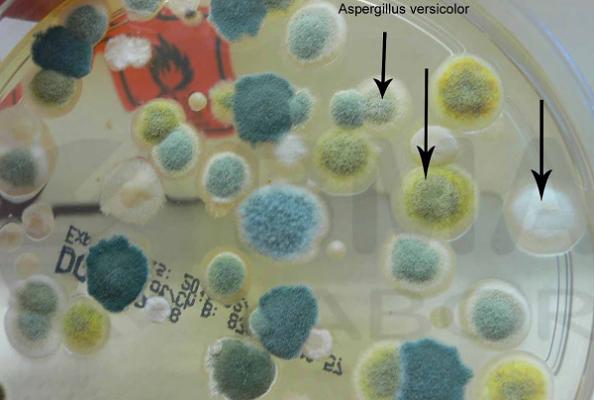
Sachverständigenbüro für Schimmelpilz und Raumausstattung Peter Berner

Otto Rainer Riester
30. March 2026
Nach einem Wasserschaden in meiner Wohnung hat mich Herr Berner bezüglich der vielfältigen notwendigen Reparatur- und Sanierungsarbeiten telefonisch und schriftlich beraten. Herr Berner arbeitet sehr professionell und umsichtig. Sein schriftlicher Bericht mit Bildern, Messwerten und Ratschlägen ist systematisch, übersichtlich und äußerst hilfreich. Durch seinen objektiven, unabhängigen Bericht habe ich eine optimale Entscheidungsgrundlage für die Auftragsvergabe zur Sanierung der Wohnung. Dies spart mir Zeit und Geld. Fünf Sterne ***** für die Arbeit von Herrn Berner.